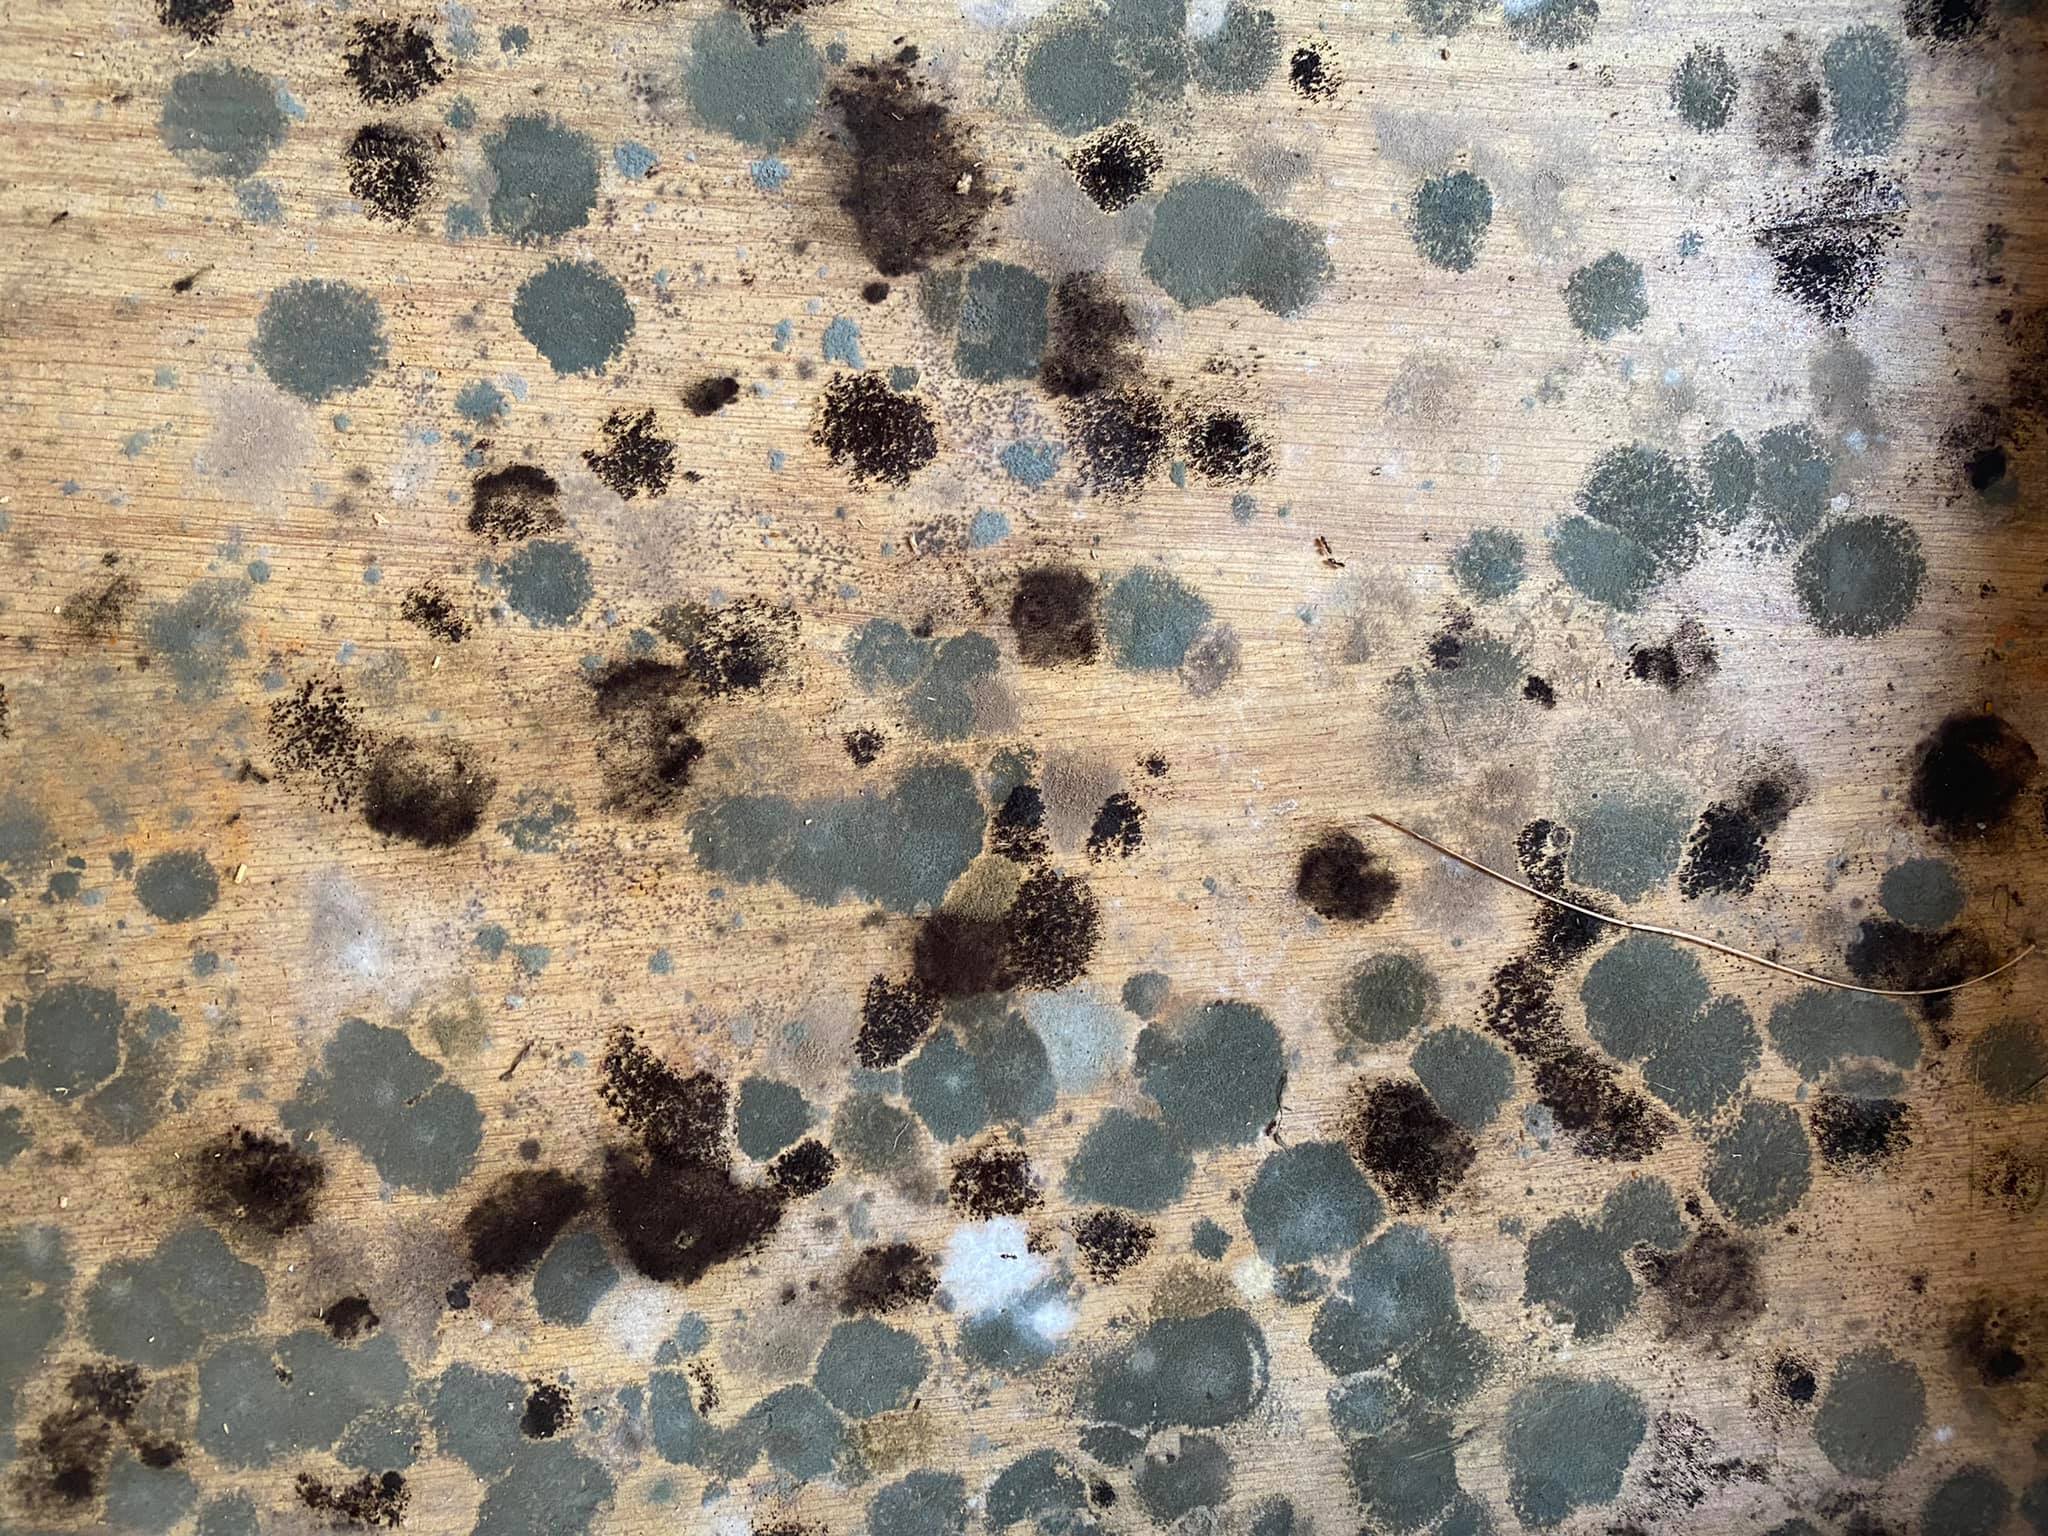

Applied Remediation Solutions
(304) 268-9870
Hedgesville, West Virginia, 25427
Business hours
| Monday | 8:00am to 5:00pm |
| Tuesday | 8:00am to 5:00pm |
| Wednesday | 8:00am to 5:00pm |
| Thursday | 8:00am to 5:00pm |
| Friday | 8:00am to 5:00pm |
About us
ARS was founded in 2001 to fill the gap between the large franchise companies with their Ins claims and the residential owner who cant afford Ins pricing. We are Expert Specialists in Mold Remediation not generalist like the large companies. Our experience covers 24 years and all phases of Restoration, but focused on Mold and all phases of Indoor Air Quality and Health. We can Inspect and figure out your homes IAQ and work to remediate and keep your home healthy. Our only goal is your satisfaction and health! We strictly follow IICRC s520 guidelines for Mold Remediation and understand home construction and Indoor Air issues. We offer air sampling and swab testing if requested to provide the most thorough service.
| Tags | Mold removal near me, Mold removal in basement, Mold removal in crawlspace, Best mold removal company, Professional mold remediation, Residential mold removal, Commercial mold remediation, Certified mold removal services, Mold inspection and testing, Basement mold treatment, Crawlspace mold cleanup, Mold prevention services, Emergency mold removal, Affordable mold remediation, Local mold removal expert, Indoor air quality remediation, Black mold removal, Mold damage repair, Trusted mold remediation company |
| Services | Water damage-related mold removal, mold removal |